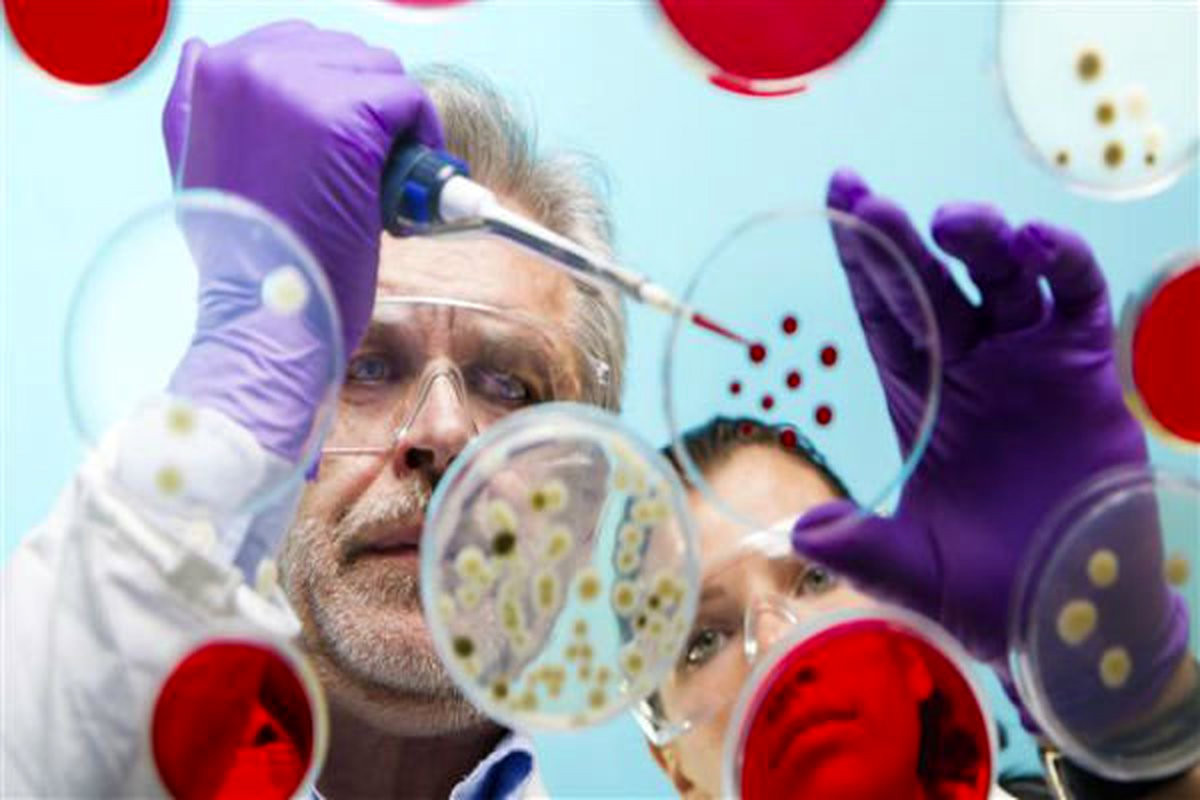
نامه بین المللی پزشکان ایرانی: آزمایشگاه‌های بیولوژیک آمریکا را نابود کنید

نامه بین المللی پزشکان ایرانی: آزمایشگاههای بیولوژیک آمریکا را نابود کنید
جمعی از پزشکان ایرانی خطاب به روسای جمهور کشورهای منطقه:برای تخریب همه آزمایشگاههای بیولوژیک آمریکا در منطقه اقدام کنید
جمعی از پزشکان ایرانی با اشاره به شیوع ویروس کرونا و فرضیه دستکاری شدن کووید۱۹ در آزمایشگاههای بیولوژیک و حمله بیولوژیک آمریکا خواستار تخریب آزمایشگاههای بیولوژیک امریکا در منطقه شدند.
به گزارش خبرنگار مهر، جمعی از پزشکان ایرانی متخصص و فوق تخصص بیماریهای عفونی، ریه، آسم وآلرژی با انتشار نامهای خطاب به رؤسای کشورهای منطقه با توجه به قوت گرفتن این فرضیه که شیوع ویروس کرونا، مبتنی بر حمله بیولوژیک امریکا بوده است، از رؤسای کشورهای منطقه خواستند به تخریب آزمایشگاههای بیولوژیک امریکا در منطقه اقدام کنند.
متن این نامه به شرح زیر است:
«سرکار خانم سالومه زورابیشویلی، رئیس جمهور محترم گرجستان
جناب آقای برهم صالح رئیس جمهور محترم عراق
جناب آقای سورنبای جینبکف رئیس جمهور محترم جمهوری قرقیزستان
جناب آقای قاسم جومارت توقایف رئیس جمهور محترم قزاقستان
جناب آقای عارف علوی رئیس جمهور محترم پاکستان
جناب آقای اشرف غنی رئیس جمهور محترم افغانستان
با سلام و احترام
همانگونه که مستحضرید این روزها تقریباً کل دنیا و کل منطقه ما درگیر مبارزه با شیوع Coronaviruses یا همان ۱۹-COVID شده است؛ ما جمعی از پزشکان ایرانی متخصص و فوق تخصص بیماریهای عفونی (infectious disease )، ریه (pulmonologist)، آسم وآلرژی (Asthma & Allergy) این روزها شاهد بیماری بسیاری از هموطنانمان بر اثر ابتلاء به این ویروس و مانند همه پزشکان دنیا در حال تلاش شبانه روزی برای درمان و نجات جان این عزیزان هستیم.
اما شواهد و اخبار متعددی هم در مقالات علمی معتبر دنیا و هم در رسانهها به نقل از کارشناسان و متخصصان ژنتیک و بیولوژی و هم در اسناد ویکی لیکس منتشر شده است که فرضیه دستکاری شدن کووید -۱۹ (Manipulated virus) در آزمایشگاههای بیولوژیک و حمله بیولوژیک (Biological attack) ایالات متحده آمریکا به وسیله این ویروس به کشورهای رقیب را به شدت تقویت میکند.
در جدی ترین و رسمیترین موضع، سخنگوی وزارت امورخارجه چین روز دوشنبه ۱۶ مارس (March) اعلام کرد، دلایلی وجود دارد که ثابت میکنند ویروس کرونا از سوی دانشمندان آمریکایی در سال ۲۰۱۵ تولید و شیوع پیدا کرده است. آمریکا، چین را در جریان جمعآوری اطلاعات در حوزه ویروس کرونای جدید قرار داد و دانشمندان چین در آرشیو خود مقاله منتشر شده در سال ۲۰۱۵ در مجله "Nature Medicine" پیدا کردند مبنی بر اینکه دانشمندان آمریکایی توانستند نوع جدید ویروس کرونا را شناسایی کنند که تأثیری مستقیم در انسان دارد.
سرکار خانم و عالیجنابان؛
با توجه به مباحث پیش آمده درمورد نقش ایالات متحده در تولید کروناویروس جدید، ضروری است به خاطر حفظ جان انسانها و برای اینکه آیندگان ما و شما را به خاطر سکوت و اهمال احتمالی مان نسبت به این جنایت بزرگ در تاریخ بشریت، شماتت نکنند، سابقه سیاه ایالات متحده در استفاده از تسلیحات بیولوژیک را هم مد نظر قرار دهید تا به یک تصمیم درست و همه جانبه در این شرایط برسید.
سابقه ایالات متحده در بکارگیری حملات بیولوژیک در ایالات متحده آمریکا یک برنامه پژوهش و توسعه تسلیحات بیولوژیکی تحت مدیریت یک سازمان غیرنظامی (the War Reserve Service) در سال ۱۹۴۲ به دستور فرانکلین روزولت رئیسجمهور وقت در کمپدتریک مریلند شروع شد و این شیوه از جنگ تا امروز علیه کشورهایی که منافع این کشور را به خطر میاندازد در دستور کار قرار گرفت.
آمریکا با تولید سلاحهای بیولوژیکی مانند باکتری باسیلوس آنتراسیس عامل بیماری سیاهزخم، فرانسیلا تولارنسیس باکتری عامل بیماری تولارمی یا تب خرگوش، بروسلا باکتری عامل بیماری تب مالت، باکتری کوکسیلا بورنتی عامل بیماری تب کیو، ویروس عامل آنسفالیت اسب ونزوئلایی، سم بوتولینیوم عامل بیماری بوتولیسم و عامل بیماریآنتروتوکسین B استافیلوکوکی، ویروس ابولا حملاتی را در نقاط مختلف جهان انجام داده است، البته این موارد جدای از حمله شیمیایی به هیروشیما و ناکازاکی است.
تأسف بار آنکه این کشور، برای آزمایش سلاحهای بیولوژیک خود، بارها جان شهروندان آمریکایی را نیز به خطر انداخته است. تنها به عنوان نمونه در سال ۲۰۰۸، دفتر پاسخگویی دولت آمریکا اذعان کرد که بهعلت آزمایشهای پروژه ۱۱۲ که در سال ۱۹۶۲ اجرا شده بود و سایر آزمایشها، دهها هزار غیرنظامی ممکن است در معرض عوامل بیولوژیکی قرار گرفته باشند؛ ارتش این کشور منکر آلوده شدن افراد شده است، اما آزمایشهای گرفتهشده از افراد نشان داد که برخی از افراد سالها از بیماریهای عفونی رنج میبرند.
عالیجنابان و سرکار خانم؛
مرکز کنترل و پیشگیری از بیماریها در آمریکا (CDC) عوامل میکروبی مورد استفاده در سلاحهای بیولوژیک را بر حسب میزان خطر حاصل از کاربرد آنها، در سه طبقه قرار داده است: A، B و C؛ و ویروسهایی نظیر ویروس آنفولانزا (H۱N۱ )، ویروس HIV و ویروس سارس را که به عفونت تنفسی شدید ایجاد میکند را در دسته C قرار داده است. این دسته شامل میکروارگانیسم های نوظهور و شدیداً بیماریزایی هستند که به خاطر در دسترس بودن و قدرت تکثیر و انتشار آسان، میتوانند با فناوریهای زیستی طوری تغییر یابند که به عنوان ارگانیسمهای مرگبار در جنگ افزارهای بیولوژیک قابل استفاده شوند.
یکی از دلایلی که میتوان COVID-۱۹ را ساخت آزمایشگاههای بیولوژیک دانست، شباهتهای عجیب آن به بیماری سارس است. سارس یک بیماری حاد تنفسی بود که سال ۲۰۰۲ در چین باعث ابتلای بیش از هشت هزار نفر و مرگ ۷۷۴ نفر از آنها در جهان شد. سارس از بیماریهایی است که تقریباً اثبات شد با دستکاری ژنتیکی حاصل شده است. این بیماری، یک سندروم حاد تنفسی است که با تب بالا، لرز، سردرد، بیحالی و بدندرد شروع میشود. بعد از مدتی، بیمار دچار سرفههای خشک شده که میتواند پیشروی کرده و منجر به اشکالات تنفسی و کمبود اکسیژن در خون نیز بشود. علائم آزمایشگاهی آن، رادیوگرافی قفسهسینه است که نمایانگر ذاتالریه است و همچنین آزمایش خون، کاهش میزان پلاکت و کاهش گلبولهای سفید را نشان میدهد و مشاهدات ما در بیمارستانها نشان میدهد در معمولیترین حالت ویروس کرونا، باعث سرماخوردگی میشود، اما در مواردی باعث سندروم حاد تنفسی یا همان «سارس» میشود.
از سوی دیگر سابقه ایالات متحده در عدم پای بندی به تعهدات بین المللی نیز سابقه سیاهی است. نمونه بارز آن را امروز هموطنان ما با گوشت و پوست خود لمس میکنند؛ در حالی که مطابق برجام آمریکا تعهد داد تحریمهای ظالمانه علیه مردم کشورمان به ویژه تحریم غیر انسانی دارو را بردارد، با خروج یکجانبه از توافق برجام، به هیچیک از تعهدات خود در معاهده بین المللی پای بند نمانده و هموطنان ما در این شرایط سخت شیوع بیماری، باید درد تحریم دارو را نیز تحمل کنند.
بنابراین خیلی سخت نیست باور کنیم که او بخواهد به توافقات بینالمللی برای کنترل توسعه جنگافزارهای بیولوژیک همچون پروتکل ۱۹۲۵ ژنو و کنوانسیون منع توسعه، تولید و ذخیرهسازی تسلیحات باکتریولوژیک و توکسینی ۱۹۷۲ پ ای بند باشد. آنها همچنین از امضای پروتکل منع گسترش سلاح میکروبی تا کنون سرباز زدهاند.
اما....
این سلاحهای بیولوژیک کجا تولید میشوند؟
اصلیترین آزمایشگاههای بیولوژیک نظامی آمریکا که توان تولید ویروس را دارند، «آزمایشگاههای درجه ۴» هستند. اهمیت استفاده از ابزار بیولوژیک برای آمریکاییها بهحدی است که برخی برآوردها تعداد این آزمایشگاهها را بیش از ۲۰۰ آزمایشگاه بیولوژیکی در سراسر جهان، عنوان میکنند. از جمله در کشورهای مستقل مشترکالمنافع با ایالات متحده؛ ایگور نیکولین یک دانشمند و زیستشناس روس مدعی است ویروسکرونا سلاح بیولوژیک آمریکاست که از آن برای کنار زدن دشمنان خود از جمله چین و ایران استفاده میکند. او میگوید: «در اطراف مرزهای چین، ۲۵ آزمایشگاه بیولوژیک آمریکایی فعال هستند، در قزاقستان، قرقیزستان، لائوس، ویتنام، تایوان، کره جنوبی، فیلیپین، تایلند و مالزی و حتی افغانستان و پاکستان، در همه کشورهای اطراف چین، آزمایشگاههای بیولوژیک آمریکایی وجود دارد. آمریکاییها در ظاهر به یک سری توافقنامههایی پایبند هستند، اما برای جلوگیری از وقوع فجایع در کشورشان این آزمایشگاهها را به خارج از خاک آمریکا انتقال دادهاند. ما میدانیم که اتفاقاتی مانند ویروس سیاه زخم در سال ۲۰۰۱ از پژوهشکده بیماریهای عفونی ارتش آمریکا در واشنگتن شیوع پیدا کرد.»
در جدیدترین خبر منتشر شده در این زمینه وزارت دفاع روسیه افشا کرد «پس از بررسی و تحلیل پروندههای مربوط به فعالیت یک تیم مخصوص در زمینه ساخت سلاح بیولوژیک مشخص شد که آمریکا با هدف تهیه انواع ویروسها برای کشتن انسانها و شیوع انواع بیماری آزمایشگاههایی را برای تولید سلاح بیولوژیک در کشور «گرجستان» تأسیس و فعال کرده است. وزارت دفاع روسیه همچنین فاش کرد که آمریکا چندین نمونه گیری از شهروندان روس را در ۳۰۰ آزمایشگاه جمع آوری کرده است تا از آنها برای ساخت سلاح بیولوژیک در نزدیک مرزهای روسیه استفاده کند. روسیه اقدام آمریکا در ساخت آزمایشگاههای سلاح بیولوژیک در گرجستان را نقض تمام کنوانسیونهای بینالمللی و تهدیدی برای مسکو و پکن دانسته است.»
عالیجنابان؛ سرکار خانم
با توجه به روابط نزدیک کشور شما با ایالات متحده و حضور بعضی نظامی آمریکا در خاک سرزمین شما، وقت آن رسیده تا یکبار برای همیشه تاریخ، تصمیمی تاریخ ساز و ماندگار گرفته شود. تصمیمی که برگرفته از انسانیت، نوع دوستی و عدالت باشد. تصمیمی که نام شما را برای آیندگان به عنوان قهرمانان راه امنیت، سلامت، صلح و عدالت جهانی تثبیت کند. تصمیمی قاطع برای تخریب همه آزمایشگاههای بیولوژیک آمریکا در منطقه و در کشورهای تحت حکومت شما؛ تصمیمی برای خروج نظامی آمریکا از کشورهای شما و منطقه زندگی همه ما.
بی شک امروز مساله مهم حکومتهای دنیا این است؛ ماندن در کنار ایالات متحده یا ماندن در کنار مردم ستمدیده و رنج کشیده. ماندن در کنار ظلم و خشونت یا ماندن در کنار صلح و عدالت و دوستی. انتخاب با شماست.
با آرزوی سلامتی و روزهای خوش
چهارمحال و بختیاری:
۱. دکتر حبیبی متخصص ریه دانشگاه علوم پزشکی شهرکرد
۲. دکتر میرحسینی متخصص غدددانشگاه علوم پزشکی شهرکرد
۳. دکتر شیرانی متخصص ارولوژی دانشگاه علوم پزشکی شهرکرد
۴. دکتر چوپانی متخصص ارولوژی دانشگاه علوم پزشکی شهرکرد
۵. دکتر پناهنده متخصص اطفال دانشگاه علوم پزشکی شهرکرد
۶. دکتر فتحی پور متخصص اطفال دانشگاه علوم پزشکی شهرکرد
۷. دکتر معصومی متخصص آنکلوژی دانشگاه علوم پزشکی شهرکرد
۸. دکتر لیلا خواجه علی متخصص ریه
۹. دکتر فریدون رحمانی متخصص عفونی
۱۰. دکتر ابوالفضل خوشدل متخصص اطفال
۱۱. دکترناصرخسروی متخصص عفونی
گیلان:
۱۲. دکتر حامد نوری متخصص داخلی
۱۳. دکتر میترا نوروزی متخصص زنان
۱۴. دکتر شاهین فردکیا متخصص عفونی
۱۵. دکتر آریا همتی نژآد متخصص جراح عمومی
۱۶. دکتر شهلا یاریان متخصص عفونی
یزد:
۱۷. دکتر شریف یزدی متخصص بیماریهای عفونی دانشگاه علوم پزشکی شهید صدوقی یزد
۱۸. دکتر آخوندیزدی متخصص بیماریهای عفونی دانشگاه علوم پزشکی شهید صدوقی یزد
۱۹. دکتر ملاعابدین متخصص بیماریهای عفونی دانشگاه علوم پزشکی شهید صدوقی یزد
۲۰. دکتر محمدی متخصص بیماریهای عفونی دانشگاه علوم پزشکی شهید صدوقی یزد
۲۱. دکتر قاسمی راد متخصص بیماریهای عفونی دانشگاه علوم پزشکی شهید صدوقی یزد
۲۲. دکتر شریفی متخصص بیماریهای عفونی دانشگاه علوم پزشکی شهید صدوقی یزد
خراسان شمالی:
۲۳. دکتر علی یوسفی فوق تخصص عفونی دانشگاه علوم پزشکی خراسان شمالی
۲۴. سید احمد هاشمی فوق تخصص عفونی دانشگاه علوم پزشکی خراسان شمالی
۲۵. محمد وثوقی فوق تخصص آسم و آلرژی دانشگاه علوم پزشکی خراسان شمالی
۲۶. ملیحه آرش نیا فوق تخصص عفونی دانشگاه علوم پزشکی خراسان شمالی
اردبیل:
۲۷. دکتر جعفر محمدشاهی متخصص بیماریهای عفونی
۲۸. دکتر حسن قبادی متخصص ریه
۲۹. دکتر ایرج فیضی جراحی ریه
۳۰. دکتر هادی پیری متخصص میکروبیولوژی
۳۱. دکتر سیدسعید حسینی متخصص ژنتیک
۳۲. دکتر محسن ارزنلو متخصص ویروس و انگل شناسی
البرز:
۳۳. دکتر عباس معینی متخصص ریه
۳۴. دکتر الهام محمدحسینی متخصص ریه
۳۵. دکتر حسن صداقت متخصص بیماریهای عفونی
۳۶. دکتر ابوالقاسم افسر متخصص داخلی
۳۷. دکتر علی ملکزاده متخصص بیماریهای عفونی و ویروس شناس
مرکزی:
۳۸. دکترسید محمدجمالیان متخصص مسمومیتها رئیس دانشگاه علوم پزشکی اراک
۳۹. دکترمجید اکبری متخصص میکروب شناسی دانشگاه علوم پزشکی اراک
۴۰. دکتراسماعیل مشیری متخصص بیهوشی ومراقبتهای ویژه دانشگاه علوم پزشکی اراک
۴۱. دکترعلیرضا کمالی متخصص بیهوشی و مراقبتهای ویژه دانشگاه علوم پزشکی اراک
۴۲. دکترمهدی صالحی متخصص طب سنتی دانشگاه علوم پزشکی اراک
آذربایجان شرقی:
۴۳. دکتر احد قلمی
۴۴. دکتر علیرضا فرشی آذر
۴۵. دکتر جواد احمدیان
۴۶. دکتر محمد ایرجیان
۴۷. دکتر خداداد خدادادی
فارس:
۴۸. دکتر محمد علی داورپناه فوق تخصص عفونی
۴۹. دکتر محمد رحیم کدیور فوق تخصص عفونی
۵۰. دکتر غلامرضا پوردادفر فوق تخصص عفونی
۵۱. دکتر محمد علی قیومی فوق تخصص عفونی
۵۲. دکتر مهرداد محرابی فوق تخصص عفونی
۵۳. دکتر حسین اسماعیل زاده فوق تخصص ریه
۵۴. دکتر مهدی دهدشتی میکروبیولوژیست
۵۵. دکتر جواد رنجبر میکروبیولوژیست
۵۶. دکتر ابوطالب نیک پور میکروبیولوژیست
قم:
۵۷. دکتر مجید محبی متخصص بیهوشی و مراقبتهای ویژه
آذربایجان غربی:
۵۸. دکتر پیمان رفیع الدین متخصص عفونی
۵۹. دکتر سید جلیل موسوی متخصص عفونی
۶۰. دکتر وحید حسین پور متخصص طب اورژانس
۶۱. دکتر سلطان پور متخصص طب اورژانس
۶۲. دکتر مرتضی متذکر متخصص ویروس شناسی
۶۳. دکتر انزلی متخصص طب اورژانس
قزوین:
۶۴. دکتر نجاری متخصص عفونی، معاون بهداشتی دانشگاه علوم پزشکی قزوین
۶۵. دکتر علی قاسمی برقی متخصص عفونی، هیأت علمی دانشگاه علوم پزشکی قزوین
۶۶. دکتر بیژنی متخصص عفونی، هیأت علمی دانشگاه علوم پزشکی قزوین
۶۷. دکتر علی بندرچی متخصص پاتالوژی و ویروس شناس
۶۸. دکتر علیرضا فراست متخصص ژنتیک و ویروس شناس
۶۹. خانم دکتر مریم جوادی متخصص علوم غذایی و تغذیه، رییس گروه تغذیه دانشگاه علوم پزشکی قزوین
کهگیلویه و بویر احمد:
۷۰. دکتر محمد علی فلاحت بیولوژیست دانشگاه علوم پزشکی یاسوج
۷۱. دکتر سید ذاکر سعیدی نژاد متخصص عفونی دانشگاه علوم پزشکی یاسوج
۷۲. دکتر صفورا حجازی متخصص پاتولوژی، دانشگاه علوم پزشکی یاسوج
۷۳. دکتر محمد یزدانپناه دانشگاه علوم پزشکی یاسوج
۷۴. دکتر مریم مهدی پور توانا دانشگاه علوم پزشکی یاسوج
هرمزگان:
۷۵. دکتر احمد زائری، میکروبیولوژیست دانشگاه پیام نور هرمزگان
۷۶. دکتر احمد همایی، بیوشیمیست دانشگاه علوم پزشکی هرمزگان
۷۷. دکتر نجاتی، متخصص بیوژنتیک دانشگاه علوم پزشکی هرمزگان
همدان:
۷۸. دکتر فرید عزیزی جلیلیان دکترای تخصصی ویروس شناسی دانشگاه علوم پزشکی همدان
۷۹. دکتر مهدی مجذوبیان دکترای تخصصی ویروس شناسی دانشگاه علوم پزشکی همدان
۸۰. دکتر میعاد بنای گلریزی میکروبیولوژیست با تخصص قارچ شناسی پزشکی
خراسان جنوبی:
۸۱. دکتر شکوه غفاری متخصص ویروس شناسی
۸۲. دکتر داوود جوانمرد متخصص ویروس شناسی
۸۳. دکتر مسعود ضیایی متخصص بیماریهای عفونی
۸۴. دکتر آزاده ابراهیم زاده متخصص بیماریهای عفونی
۸۵. دکتر زهره آذرکار متخصص بیماریهای عفونی
ایلام:
۸۶. دکتر جهانگیر عبدی ویروس شناس
۸۷. دکترعباس ملکی ویروس شناس
۸۸. دکتر علی عمار لویی ویروس شناس
۸۹. دکتر حمید تقی نژاد ویروس شناس
۹۰. دکتر مصطفی شنبهای ویروس شناس
زنجان:
۹۱. دکتر امیرحسین مقتدر متخصص بیماریهای عفونی
۹۲. دکتر امیرحسین شکوری متخصص داخلی
۹۳. دکتر محمد جعفرزاده متخصص بیماریهای عفونی
۹۴. دکترحبیب الله طاهرخانی متخصص داخلی
۹۵. دکتر مشهود تقی لو متخصص گوش، حلق و بینی
.۹۶ دکتر جلیلیان تخصص ویروس شناسی
.۹۷ دکتر توکل تخصص ریه
.۹۸ دکتر امین ترابی پور تخصص ریه
.۹۹ دکتر کرمی تخصص بهداشت
.۱۰۰ خانم دکتر حیدرآزاد متخصص کودکان
.۱۰۱ دکتر ترابی زاده تخصص بهداشت و آموزشهای بهداشتی
.۱۰۲ دانشگاه علوم پزشکی جندی شاپور اهواز_خوزستان








دیدگاه تان را بنویسید